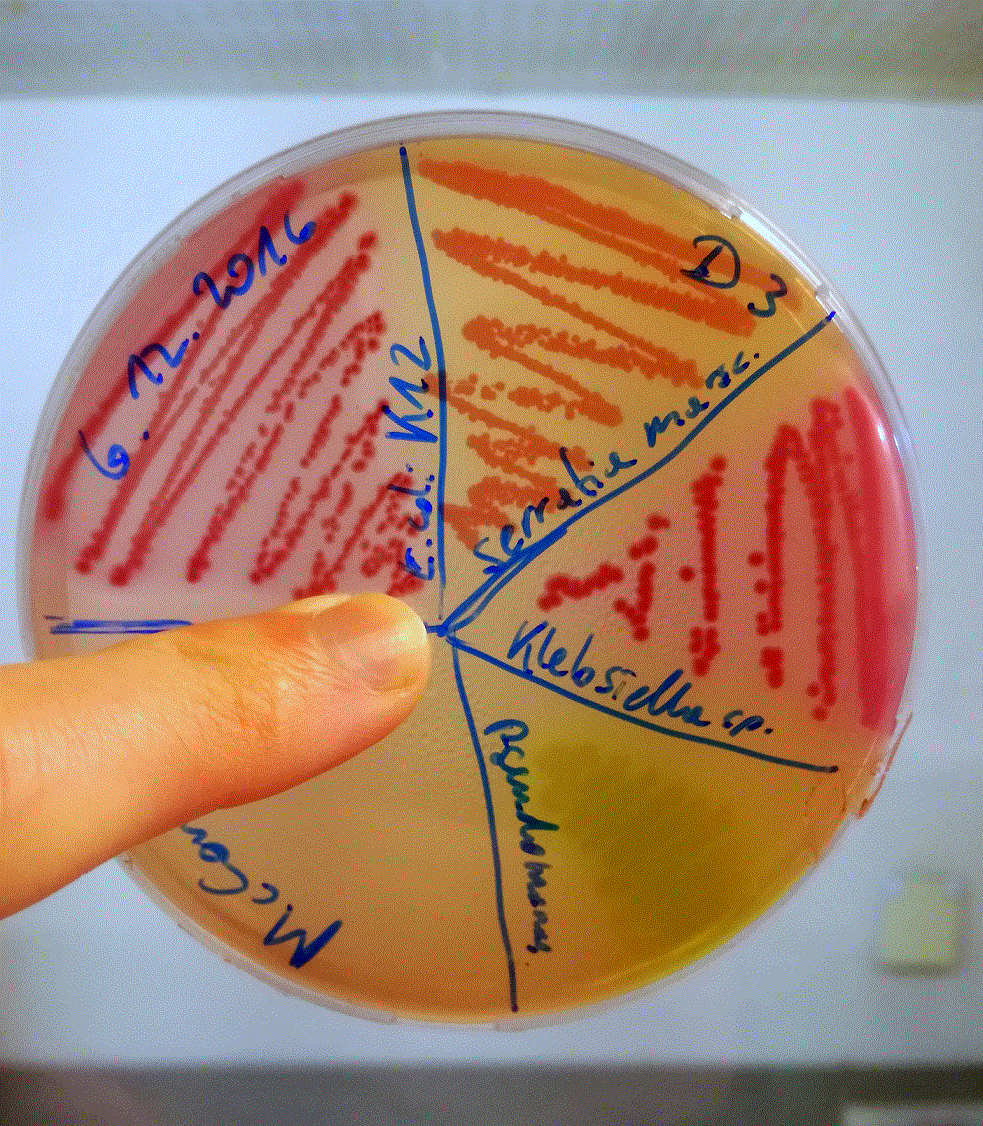

This is an old revision of the document!
Daniel Derndorfer (D3)
“Active Biohacker” & Student of Molecular Microbiology and Applied Ethics.
About me:
Working (for fun and knowledge) on different projects all around microbiology, biohacking methods and lab safety for the Open bioLab Graz Austria.
I like to find an interessting question and try to look for answers. Sure, I want to work in the field of scientific research, but I see a lot of potential for free knowledge and self-education in the biohacking sector. You can think of them as two independent ways to do science, which do not contradict each other and may also overlap. Also with upcoming technologies in the field of life sciences like CRISPR/Cas9 and the misuse of antibiotika in our society we need to think about how we should act as biohackers in the future. Therefore I also claim for "the way of responsible biohacking".
Projects at r3 and OLGA:
- Aufbau und Organisation vom Open bioLab Graz Austria (OLGA) im r3
- Organisation und Leitung von OLGA Veranstaltungen (Open Lab Days, der Doku- & Diskussionsabend)
- Aufbau der OLGA Stammsammlung
- Fotografische Dokumentation der Aktivitäten rund ums OLGA
- Betreuung von Social Media Kanälen (Facebook Gruppe "Open bioLab Graz Austria (OLGA)" & Instagram Account "realraum_olga")
- Erstellung von Videos rund um r3 und OLGA
- Vorbereitung und Interview für einen Beitrag einer Sendung um Biohacking und Genome Editing/CRISPR-Cas im öffentlichen-rechtlichen Rundfunk
- Interview über Biohacking und Genome Editing/CRISPR-Cas in einer österreichischen Tageszeitung (online Version)
- Partizipant beim crispr.KITCHEN Retreat, hosted by UnternehmerTUM GmbH, 2017 (Website vom Besitzer offline) mit Video über persönliche Eindrücke
- Bakterien und Mikrobiologie Projekt
- Präsentation des Bakteriophagen Projektes bei ARGE Hygiene UKH Graz
- Bioethik und Biosicherheit rund um Biohacking
- "Biohacking as possible playground for genome editing" Präsentation für die 18th Annual STS Conference 2019 (Science, Technology & Society Studies) und Poster Vorstellung der Grazer Biohacker Community
- diverse Einzelprojekte im OLGA und Erstellung von Protokollen (…Mikrobiologie, Gentechnik, Biochemie, Biotechnologie,…)
- Co-Programmierung eines MediaWiki für den Verein realraum (r3 Online Umbau Projekt)
Contact:
Email: derndorfer_d@gmx.at
Riot.im "Open Chat Room" (@–D3–Daniel_D_Dern:matrix.org)
See ya,
Daniel Derndorfer